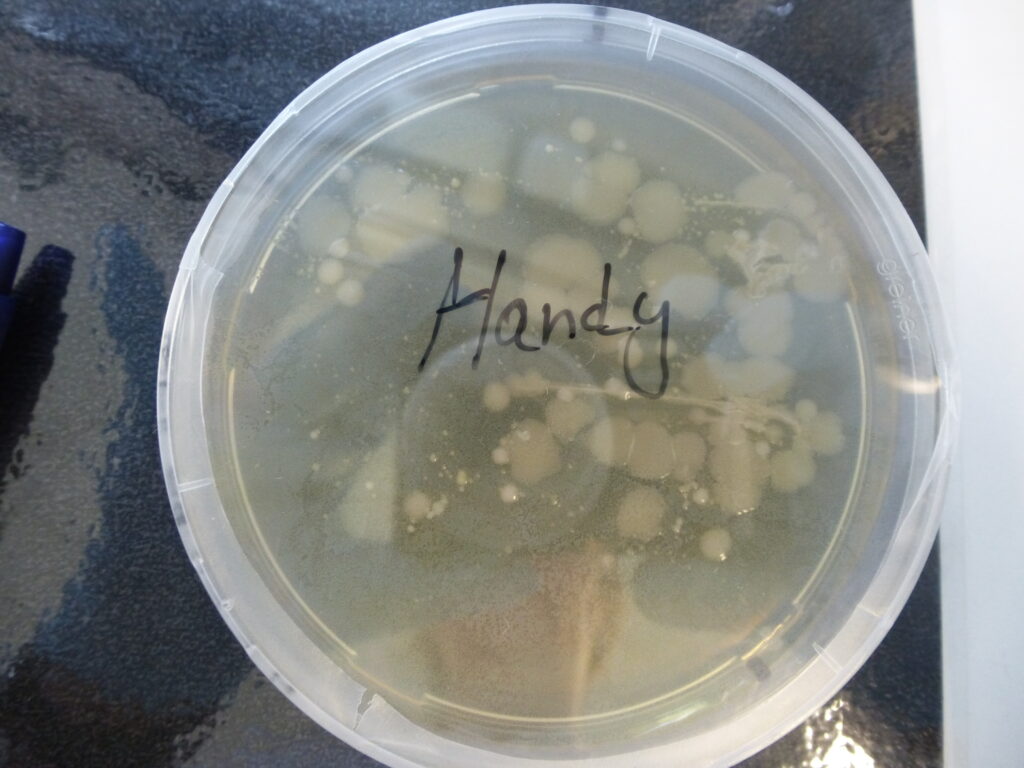

Wir, die Ernährungsklasse 11 des Beruflichen Gymnasiums, sind eingetaucht in die faszinierende Welt der Mikrobiologie!
In unserer zweitägigen Schulung im Labor des BioS haben wir erlebt, wie Mikroorganismen nachgewiesen und untersucht werden. Dabei kamen spannende Methoden zum Einsatz, die uns einen tiefen Einblick in die mikroskopische Welt der Bakterien, Pilze und Viren gewährten.


Der erste Tag begann mit einer Einführung in die verschiedenen Arten von Mikroorganismen. Das ging schon ein wenig über den Unterricht in der Schule hinaus. Im Anschluss folgte der Daumentest, bei dem wir selbst Proben von unserer Haut genommen haben. So konnten wir sehen, wie viele Mikroorganismen auf der Haut leben und wie wichtig das gründliche Waschen mit Seife bzw. das Desinfizieren der Hände in der Gemeinschaftsverpflegung ist.

Beim Abklatschtest wird das Vorhandensein von Mikroben auf verschiedenen Oberflächen untersucht. Auch hier gab es überraschende Ergebnisse…. die Trinkflasche, das Handy, die Uhr…. Mikroorganismen sind überall! Auch in der Luft!


Wir wurden ans Mikroskopieren von Proben herangeführt, um die Mikroorganismen direkt zu sehen und zu identifizieren. Auch unsere eigene Mundschleimhaut wurde dabei sichtbar gemacht.
Zudem lernten wir die Fotometrie kennen, eine präzise Methode zur quantitativen Bestimmung von Mikroorganismen in Flüssigkeiten – ein wichtiges Werkzeug in der modernen Mikrobiologie. So konnten wir eigenständig messen, ob Sauerstoff oder Kälte der Vermehrung von Mikroorganismen schadet oder hilft.
Fazit: Es waren zwei lange und anstrengende Tage, aber sie gaben uns viel praktisches Wissen und auch wertvolle Erfahrungen. Unterricht am anderen Ort ist schon auch nochmal spannend!
BGYM 25.1





